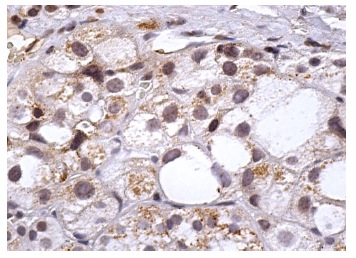

Oct3/4 Mouse Monoclonal Antibody (ARA821)
CAT.NO. : ARA6612
US$ Please choose
US$ Please choose
*产品价格可能会有所调整,请以品牌方官网实时更新的价格为准,以确保准确性。
Background
POU5F1 (POU domain, class 5, transcription factor 1), also known as octamer binding transcription factor - 3 (Oct - 3, Otf - 3), octamer - binding transcription factor - 4 (Oct - 4, Otf - 4) and Oct - 3/4, modulates embryonic stem (ES) cell populations by influencing lineage commitment. Oct - 3/4 sustains stem - cell self - renewal and differentiation pathways. Transcription factors containing the POU homeodomain regulate tissue - specific gene expression in lymphoid and pituitary differentiation and in early mammalian development. Oct - 3/4 is capable of inducing rapid proliferation and tumorigenic properties of ES cells through activation of the UTF1 gene. In humans, two Oct - 3/4 isoforms contribute to influencing the undifferentiated phenotype of ES cells. Oct - 3/4 pseudogenes localizing to human chromosomes 10 and 8 are reported to be transcribed in certain cancer cell lines and tissues.
Application
Oct - 3/4 (ARA821) is recommended for detection of Oct - 3/4 of mouse, rat and human origin by Western Blotting (starting dilution 1:200, dilution range 1:100 - 1:1000), immunoprecipitation [1 - 2 µg per 100 - 500 µg of total protein (1 ml of cell lysate)], immunofluorescence (starting dilution 1:50, dilution range 1:50 - 1:500), immunohistochemistry (including paraffin - embedded sections) (starting dilution 1:50, dilution range 1:50 - 1:500), flow cytometry (1 µg per 1 x 10⁶ cells) and solid phase ELISA (starting dilution 1:30, dilution range 1:30 - 1:3000); non cross - reactive with Oct - 3/4 isoform B.
Data

Oct - 3/4 (ARA821). Western blot analysis of Oct - 3/4 expression in F9 (A), ES - D3 (B) and NTERA - 2 cl.D1 (C) whole cell lysates.
Oct - 3/4 (ARA821). Immunoperoxidase staining of formalin fixed, paraffin - embedded human adrenal gland tissue showing nuclear staining of glandular cells .
Sourse
Oct - 3/4 (ARA821) is a mouse monoclonal antibody raised against amino acids 1 - 134 of Oct - 3/4 of human origin.
Storage
Store at 4°C, DO NOT FREEZE. Stable for one year from the date of shipment.
New Products
